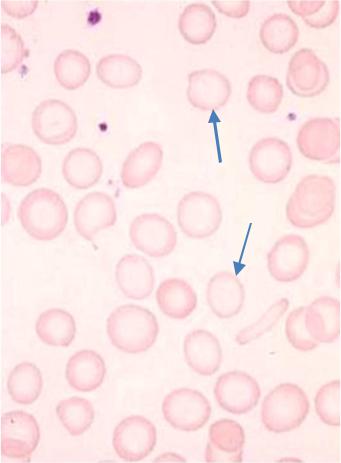
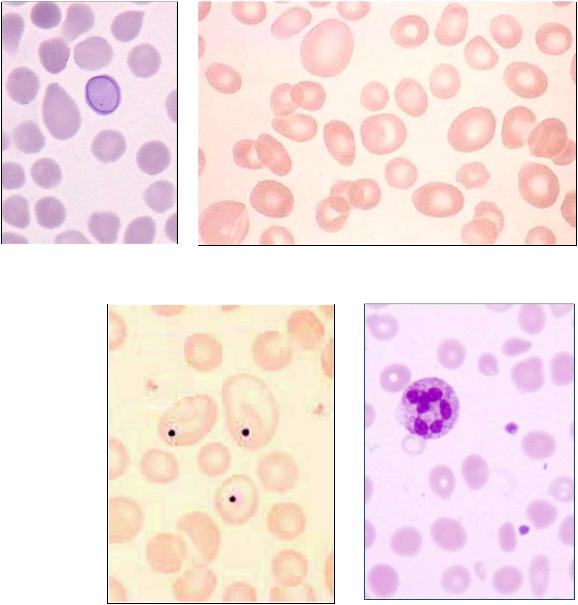

Материал: клинический+анализ+крови+2

Нормальный эритропоэз

Базофильные и полихроматофильные эритрокариоциты
Для эритропоэза характерна
очаговость, что хорошо видно в срезах с трепанобиоптата.
При активном эритропоэзе в мазках костного мозга, полученного при аспирации, часто встречаются островки эритропоэза с макрофагом в
центре (рис. слева).
Железодефицитная анемия (ЖДА)
•Гипохромная
•Микроцитарная
•Выраженный анизоцитоз
•Уменьшение железа в сыворотке крови
•Увеличение
железосвязывающей способности сыворотки крови
•Снижение процента насыщения трансферрина железом
•Снижение уровня сывороточногоферритина
Эритроциты бледные, очень большая площадь просветления, иногда окрашен только ободок (анулоциты)

Железодефицитная анемия (ЖДА)
WBC : |
5.6 |
|
103/mm3 |
‹ 3.5 |
– 10.0 › |
MCV |
: |
57 |
L |
μm3 |
‹ |
80 |
– |
97 › |
|
RBC : |
4.27 |
L |
106/mm3 |
‹ 3.80 |
– 5.80 › |
MCH |
: |
19.5 |
L |
pg |
‹ 26.5 |
– 33.5 › |
|||
HGB : |
8.3 |
L |
g/dl |
‹ 11.0 |
– 16.5 › |
MCHC |
: |
34.1 |
|
g/dl |
‹ 31.5 |
– 35.0 › |
|||
HCT : |
24.5 |
L |
% |
‹ 35.0 |
– 50.0 › |
RDW |
: |
21.7 |
Н |
% |
‹ 10.0 |
– 15.0 › |
|||
PLT : |
275 |
|
103/mm3 |
‹ 150 |
– 390 › |
MPV |
: |
8.4 |
|
μm3 |
‹ |
6.5 |
– 11.0 › |
||
PCT : |
.230 |
|
% |
‹ .100 |
– .500 › |
PDW |
: |
12.2 |
|
% |
‹ 10.0 |
– 18.0 › |
|||
WBC Flags |
: M2 G1 G2 |
|
‹ 17.0 |
– 48.0 › |
# LYN : |
1.7 |
|
103/mm3 |
‹ 1.2 |
– 3.2 |
› |
||||
DIFF |
: |
|
|
‹ 4.0 |
– 10.0 › |
# MON : |
0.5 |
|
103/mm3 |
‹ 0.3 |
– 0.8 |
› |
|||
% |
|
‹ 43.0 |
– 76.0 › |
# GRA : |
3.4 |
|
103/mm3 |
‹ 1.2 |
– 6.8 |
› |
|||||
%LYM : |
31.0 |
|
|
|
|
|
|
|
|
|
|
|
|
|
|
%MON : |
10.0 |
% |
|
|
|
|
|
|
|
|
|
|
|
|
|
%GRAN : |
59.0 |
% |
|
|
|
|
|
|
|
|
|
|
|
|
|
Кривая Прайс-Джонса
При ЖДА совпадает микроцитоз по объёму и диаметр у (кривая Прайс-Джонса).Красной линией отмечена средняя арифметическая нормы
Мегалобластная анемия
•макроцитарная
•гиперхромная
•анизоцитоз от мегалоцитов до микроцитов, есть фрагментоциты
•тельца Жолли и кольца Кэбота в эритроцитах (на рисунках слева)
•лейкопения (нейтропения)
•гиперсегментация ядер нейтрофилов (сдвиг вправо)
– внизу справа
•тромбоцитопения
•неэффективный эритропоэз (ретикулоцитопения)